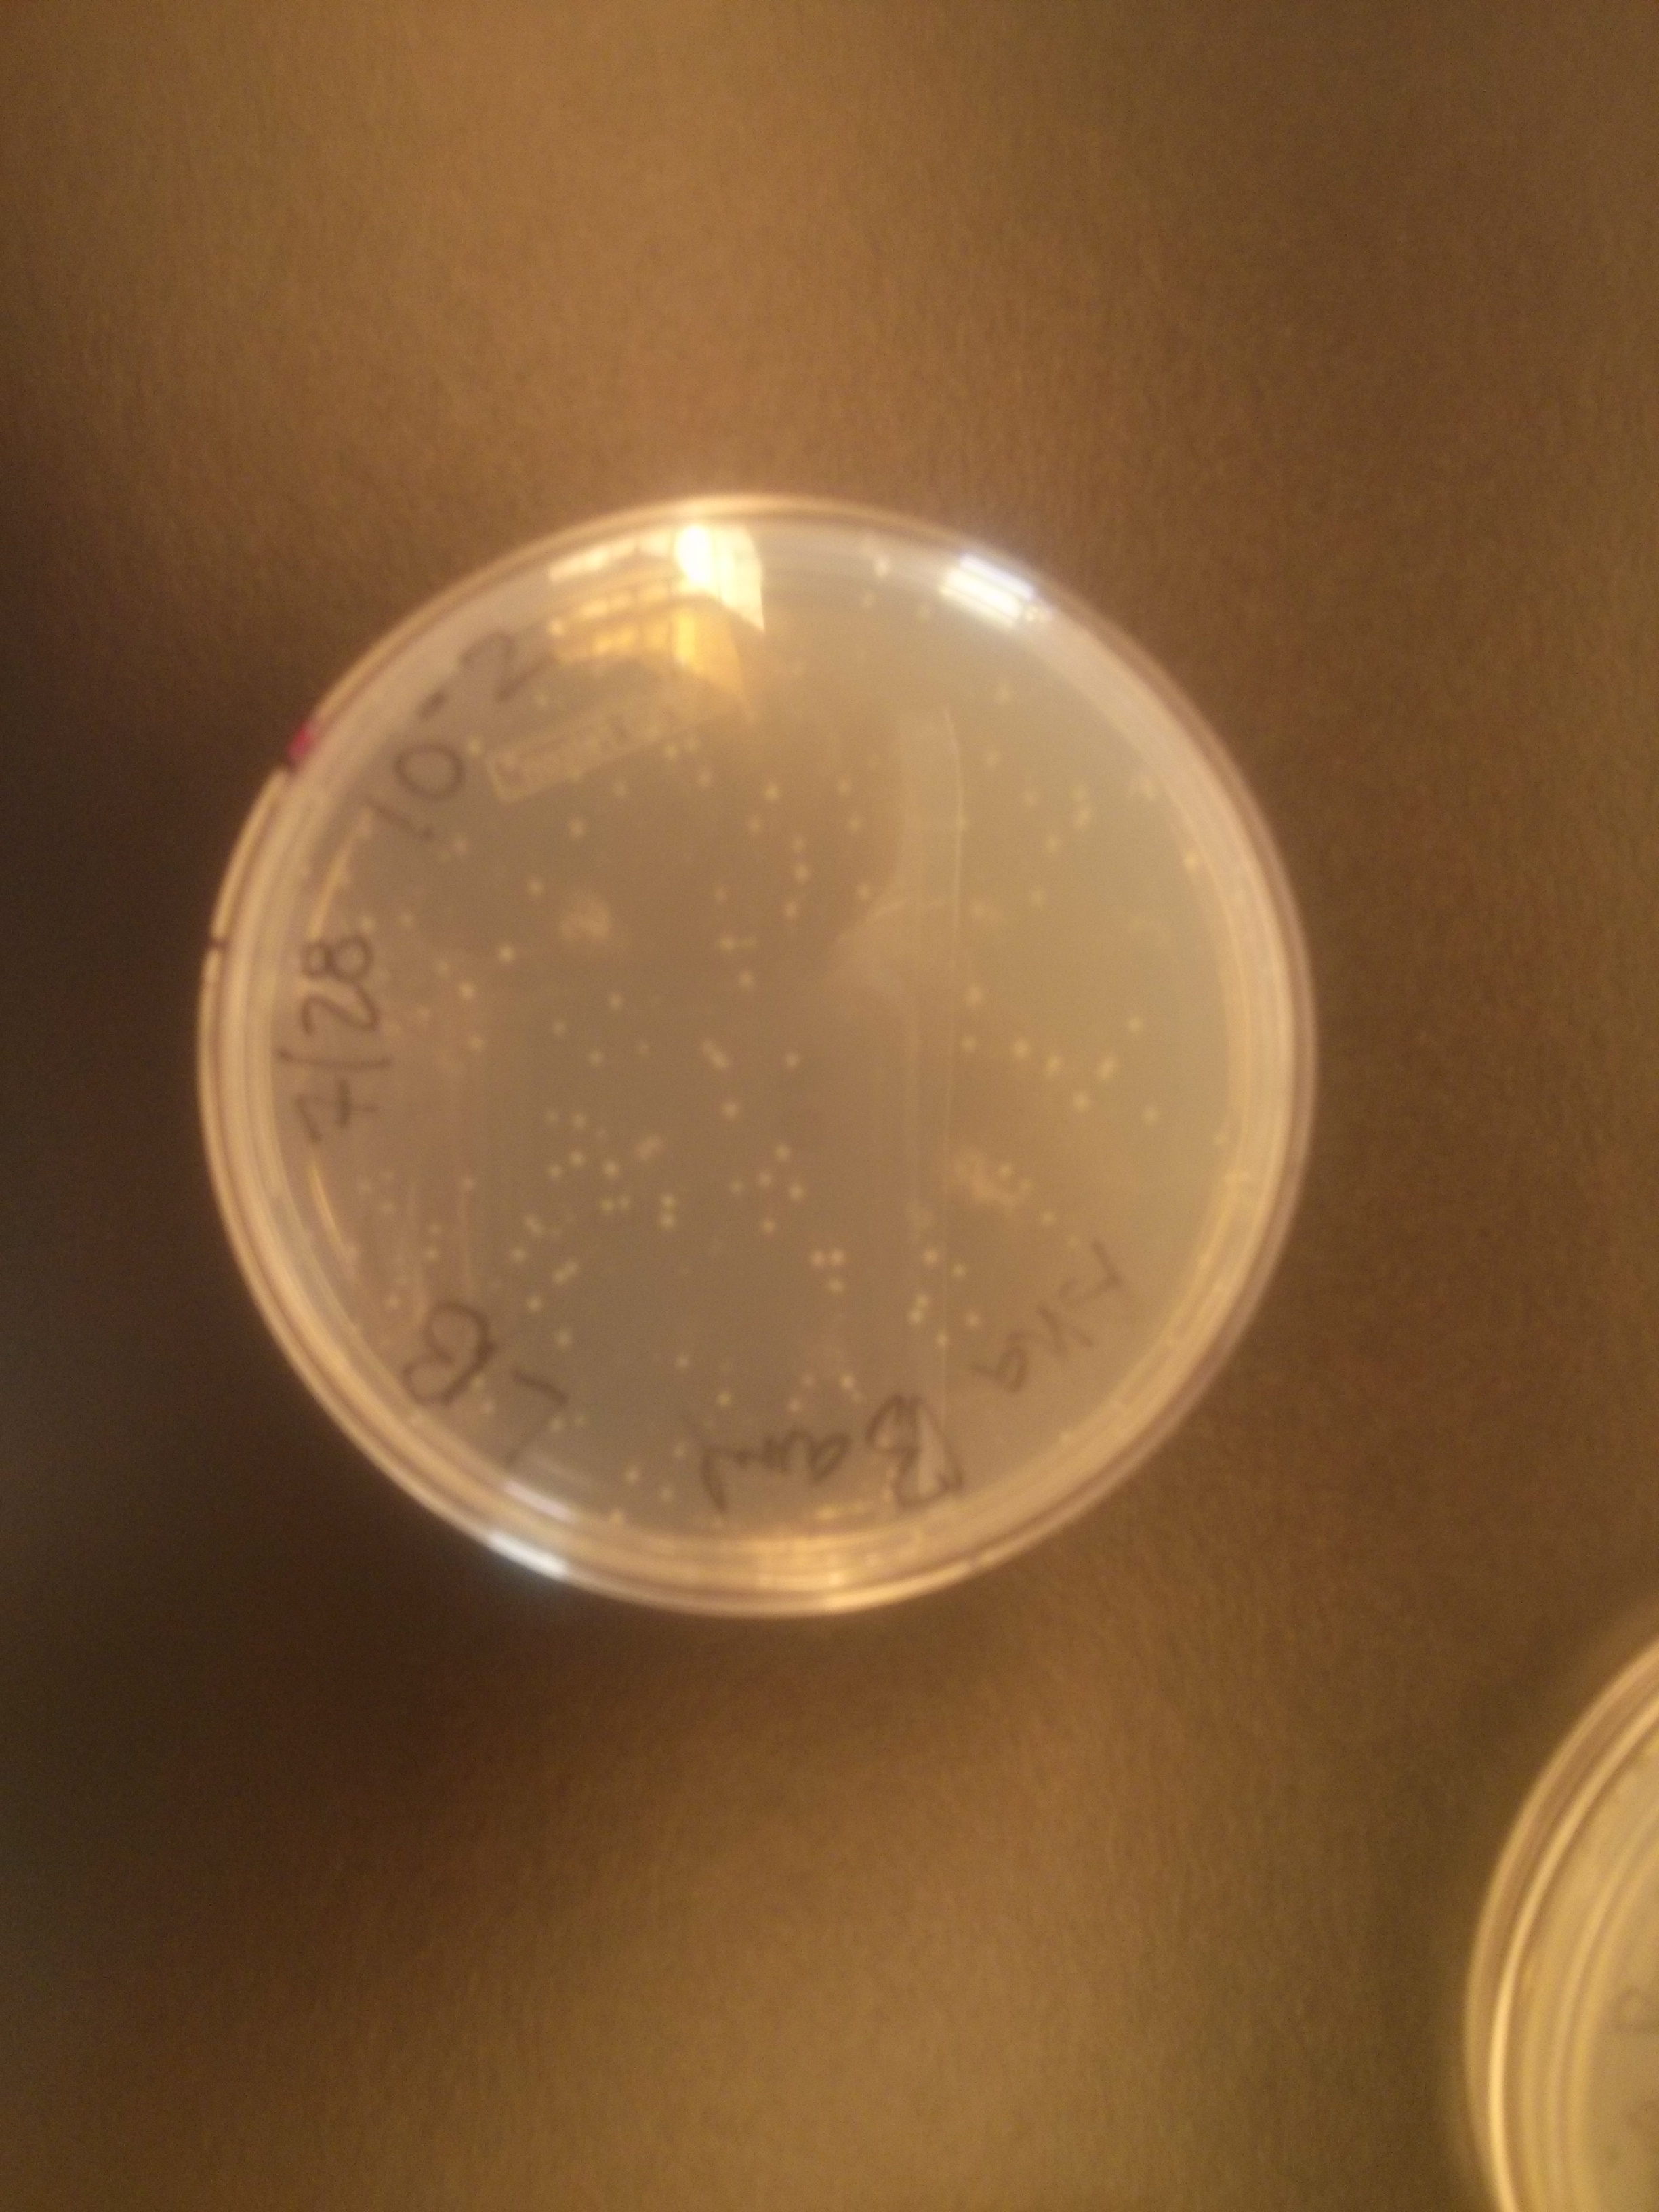

It is almost 10 pm and I am sitting in a student dormitory of Yale University, New Haven CT. My last post was from The Washington University in St. Louis, MO; in a ver similar setting. I am attending a workshop for professors to develop discovery-based lab courses.
For the record: I am here because my colleague who actually submitted the project could not attend. After the St. Louis workshop it was clear to me that driving such a project requires lots of work, and not only academic. But having our non-traditional university accepted as pilot partners is such an honor and opportunity, that I said yes when asked if I could jump in.
The initiative is driven by Jo Handelsman, whose work I have been following for a while. In real life she is even more amazing than on paper or the web. She is bright, focused, with a touch of humor and absolutely inspiring. She shared a personal history about why she felt so strongly about new antibiotics, which was moving; but also queried us on a simple chemical detail that could explain why big pharma companies have missed so many potential antibiotics. Then of course there is an amazing team, from Tiffany Tsang overseeing everything, to the poised education expertise of Jennifer Frederick and the solid laboratory knowledge of Simon Hernandez. There are more and they do more, but this is just day 2.
Tiffany created a great blog site: http://smallworldinitiative.wordpress.com/
where most of our documents are uploaded. This is also a site for ideas, comments, and general communication.
So far we have done some fun stuff in the lab: collected soil, made serial dilutions and prepared spread plates on different media. I was happy to see colonies on my LB plate today, and moved on to the next stage, pick and patch colonies. Next step will be testing for antibiotic activity, and then move on to characterization, PCR, and sequencing.
The rest of the time we sit and listen to lectures about science education, or discuss/brainstorm about the design of our future courses. While everybody is fired up, concerns abound about how to implement the courses, from time and space to powers to be. I feel very lucky that my university’s unorthodox system (one month accelerated courses in small classrooms) is actually pretty well suited for this project. We could probably make it easier in 2 months, but having long lab sessions 2-3 times/week (and nothing else) will probably make for an immersive experience. Not sure we will make it all the way to the chemical characterization of any possible compound, but it will be still amazing for our students.
This project is to be spread to the whole world…so we can explore soils everywhere in the search of new antibiotics. How cool can that be? Jo recalled that one of the richest student soil samples came from the town’s historical cemetery. Don’t you feel like going out to explore funky locations to sample soil?
I do.
Science is and has to be fun.